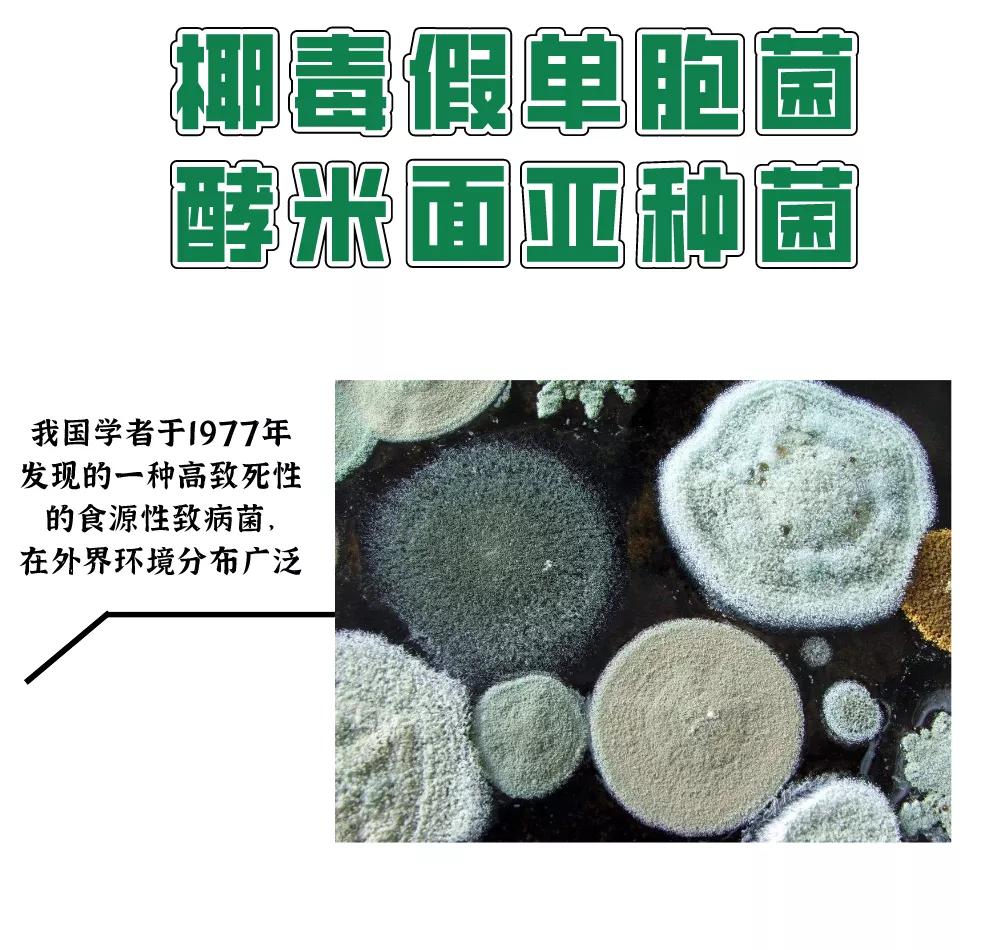
一家9口人食物中毒,一家9口食物中毒最新

2020年的最后一个假期就这么结束了。
长假期间,和家人聚在一起,煮上一桌家乡菜,弥补春节期间的遗憾,也算是一种不错的度假方式。
然而在黑龙江省鸡西市鸡东县,有这么一家人聚餐却出现意外。一家九口发生食物中毒,其中八人死亡,代价惨痛。

照片中的11个人在一顿早餐后,其中的7个人和拍照的人,都永远离开了这个世界。(图片来源自新闻在线)
让我们回到10月5日的早上。
李红艳和丈夫张某以及亲属共12人一起聚餐,其间家里长辈9人全都吃了自制的酸汤子(3个年轻人因不喜欢这种口味没吃)。
到了中午,9位食用了酸汤子的长辈陆续出现了身体不适,随即送往医院救治。
截止目前,已经有8人抢救无效身亡,1人仍在抢救中。
事后调查得知,他们所食用的酸汤子食材已在冰箱冷冻一年,疑似该食材引发食物中毒。
对于酸汤子是如何引起人体中毒的,很多医疗大V和媒体纷纷猜测,将"凶手"指向

是的,黄曲霉素是毒性极强的剧毒物质,被国际认证为一类致癌物。但它并不是造成这次群体性食物中毒的"罪魁祸首"。

图片来源于网络
10月12日晚,黑龙江卫健委最新通报表示该事件初步定性是由椰毒假单胞菌污染产生高浓度米酵菌酸引起的食物中毒。
事隔7日,在经过艰难的取证调查后,残害人命的"真凶"终于浮出水面,它就是↓


酸汤子,又称汤子、馇条,是流行于东北地区的辽宁东部、吉林东南部及黑龙江东部一带,一种用发酵面碴子做的面条状食物,是酵米面的一种,吃起来会有酸味的香气。

图片来源于网络
像这种酵米面是我国部分地区流传的一种粗粮细作的加工方法。
一般是将玉米、高粱米等加水浸泡10-30天,使其发酵、变软,再经磨浆过滤、晾晒成粉,然后制成面条、饼、饺子等食品。
在酵米面的制作发酵等过程中,容易受到一种名叫椰毒假单胞菌酵米面亚种菌的细菌污染,从而产生一种毒素—米酵菌酸。
近几年,我国发生的椰毒假单胞菌酵米面亚种引起的米酵菌酸中毒,大部分都与某些地方特色食品有关:
北方以酵米面制作的臭碴子、酸汤子、格格豆等为主,南方多以酵米面制作的汤圆和以糯米泡制后做成的吊浆粑、河粉等食品为主。

图片来源于网络
这些特色食品如果被米酵菌酸污染,一旦被人吃下,后果将不堪设想。

这么说吧,米酵菌酸↓

米酵菌酸,具有很强的生物活性,是椰毒假单胞菌引起食物中毒和死亡的主要毒性代谢产物。
它主要作用于肝、脑、肾等实质性脏器。在临床上,患者会表现为上腹部不适,恶心呕吐,轻微的腹泻,头昏,全身无力等症状。
严重的话,患者还会出现脏器损伤,表现包括黄疸、肝脾肿大、皮下出血、呕血、少尿、甚至抽搐休克等。
当人中毒后发病迅速,潜伏期一般只有30分钟—12小时(少数长达数天),能留给人就医及时接受治疗的时间并不多。
更重要的是,目前医学上对米酵菌酸尚无特效解毒药物,一旦中毒,病死率高达40%~100%。
在我国,由于米酵菌酸中毒导致器官衰竭最后死亡的事件时有发生。

最最可怕的是,米酵菌酸是一种 耐热性极强 的毒素,120℃高温处理l小时仍可保持毒性。
所以别想用煮熟食物这一招来对付它,熟食照样可以让人中毒。
很多人可能会说↓

其实除了酸汤子,在 很多常见的食物 里也能找到米酵菌酸的身影。
第一种是就谷类发酵制品 ,如湿河粉、湿米粉、发酵玉米面、糯玉米汤圆粉、玉米淀粉、发酵糯小米、吊浆粑、糍粑、醋凉粉等;
第二种是变质和泡久了的银耳、木耳 ;

图片来源于网络
第三种是变质的薯类制品 ,如马铃薯粉条、甘薯面、山芋淀粉等。
这些都是我们经常吃的食物,如果这时再加上家里长辈的"推波助澜":
比如一些处理不当的食材冻在冰箱里慢慢吃;
比如剩饭剩菜舍不得倒留着吃几天;
再比如经常DIY一些不常见的"黑暗料理"。

那米酵菌酸中毒离我们并不遥远。
那我们应该怎么办呢?
1、 最好的预防办法就是:尽量不去食用家庭自制的发酵面米食品。
2、 如果做不到第一条,那在家制备发酵面米食品时要勤换水,保持卫生,保证食物无异味产生,一旦发现粉红、绿、黄绿、黑等各色霉斑,就不能食用。磨浆后要及时晾晒或烘干成粉;贮藏要通风、防潮、防尘。
3、 每顿吃多少做多少,尽量不吃剩菜。
4、 不食用变质、发霉的木耳和银耳;干木耳和银耳泡发时应使用干净的水和容器;现泡现吃,泡发时间不宜太长,且尽量不要剩余。
5、 如果出现了中毒症状,首先停止进食,立刻催吐(用手抠),并及时就医。注意,如果吃了同样食物的人,不管有没有症状都应立即到医院检查。
最后想和大家说说,
就算一些地方特色食品再好吃,
就算再舍不得剩饭剩菜,
也没有必要用生命去冒险。
这8条人命换来的沉甸甸的教训,
我们必须要引起重视。
请转发提醒家里人注意,愿悲剧不再发生!
参考资料:
[1]2020-10-12,央视新闻,《黑龙江鸡西"酸汤子"中毒事件,死亡人数升至8人》
[2]2020-10-10,黑龙江卫健委官网,《酵米面食物中毒的预防》
[3]刘志涛,万蓉,胡太芬,吕韬,牟建春,普毅.一起椰毒假单胞菌酵米面亚种引起的食物中毒调查分析[J].职业与健康,2013,29(05):582-583.
[4]2020-10-11,白衣山猫,《黑龙江鸡东县9人聚餐7人死亡,未必是黄曲霉素中毒,很可能是米酵菌酸中毒!》